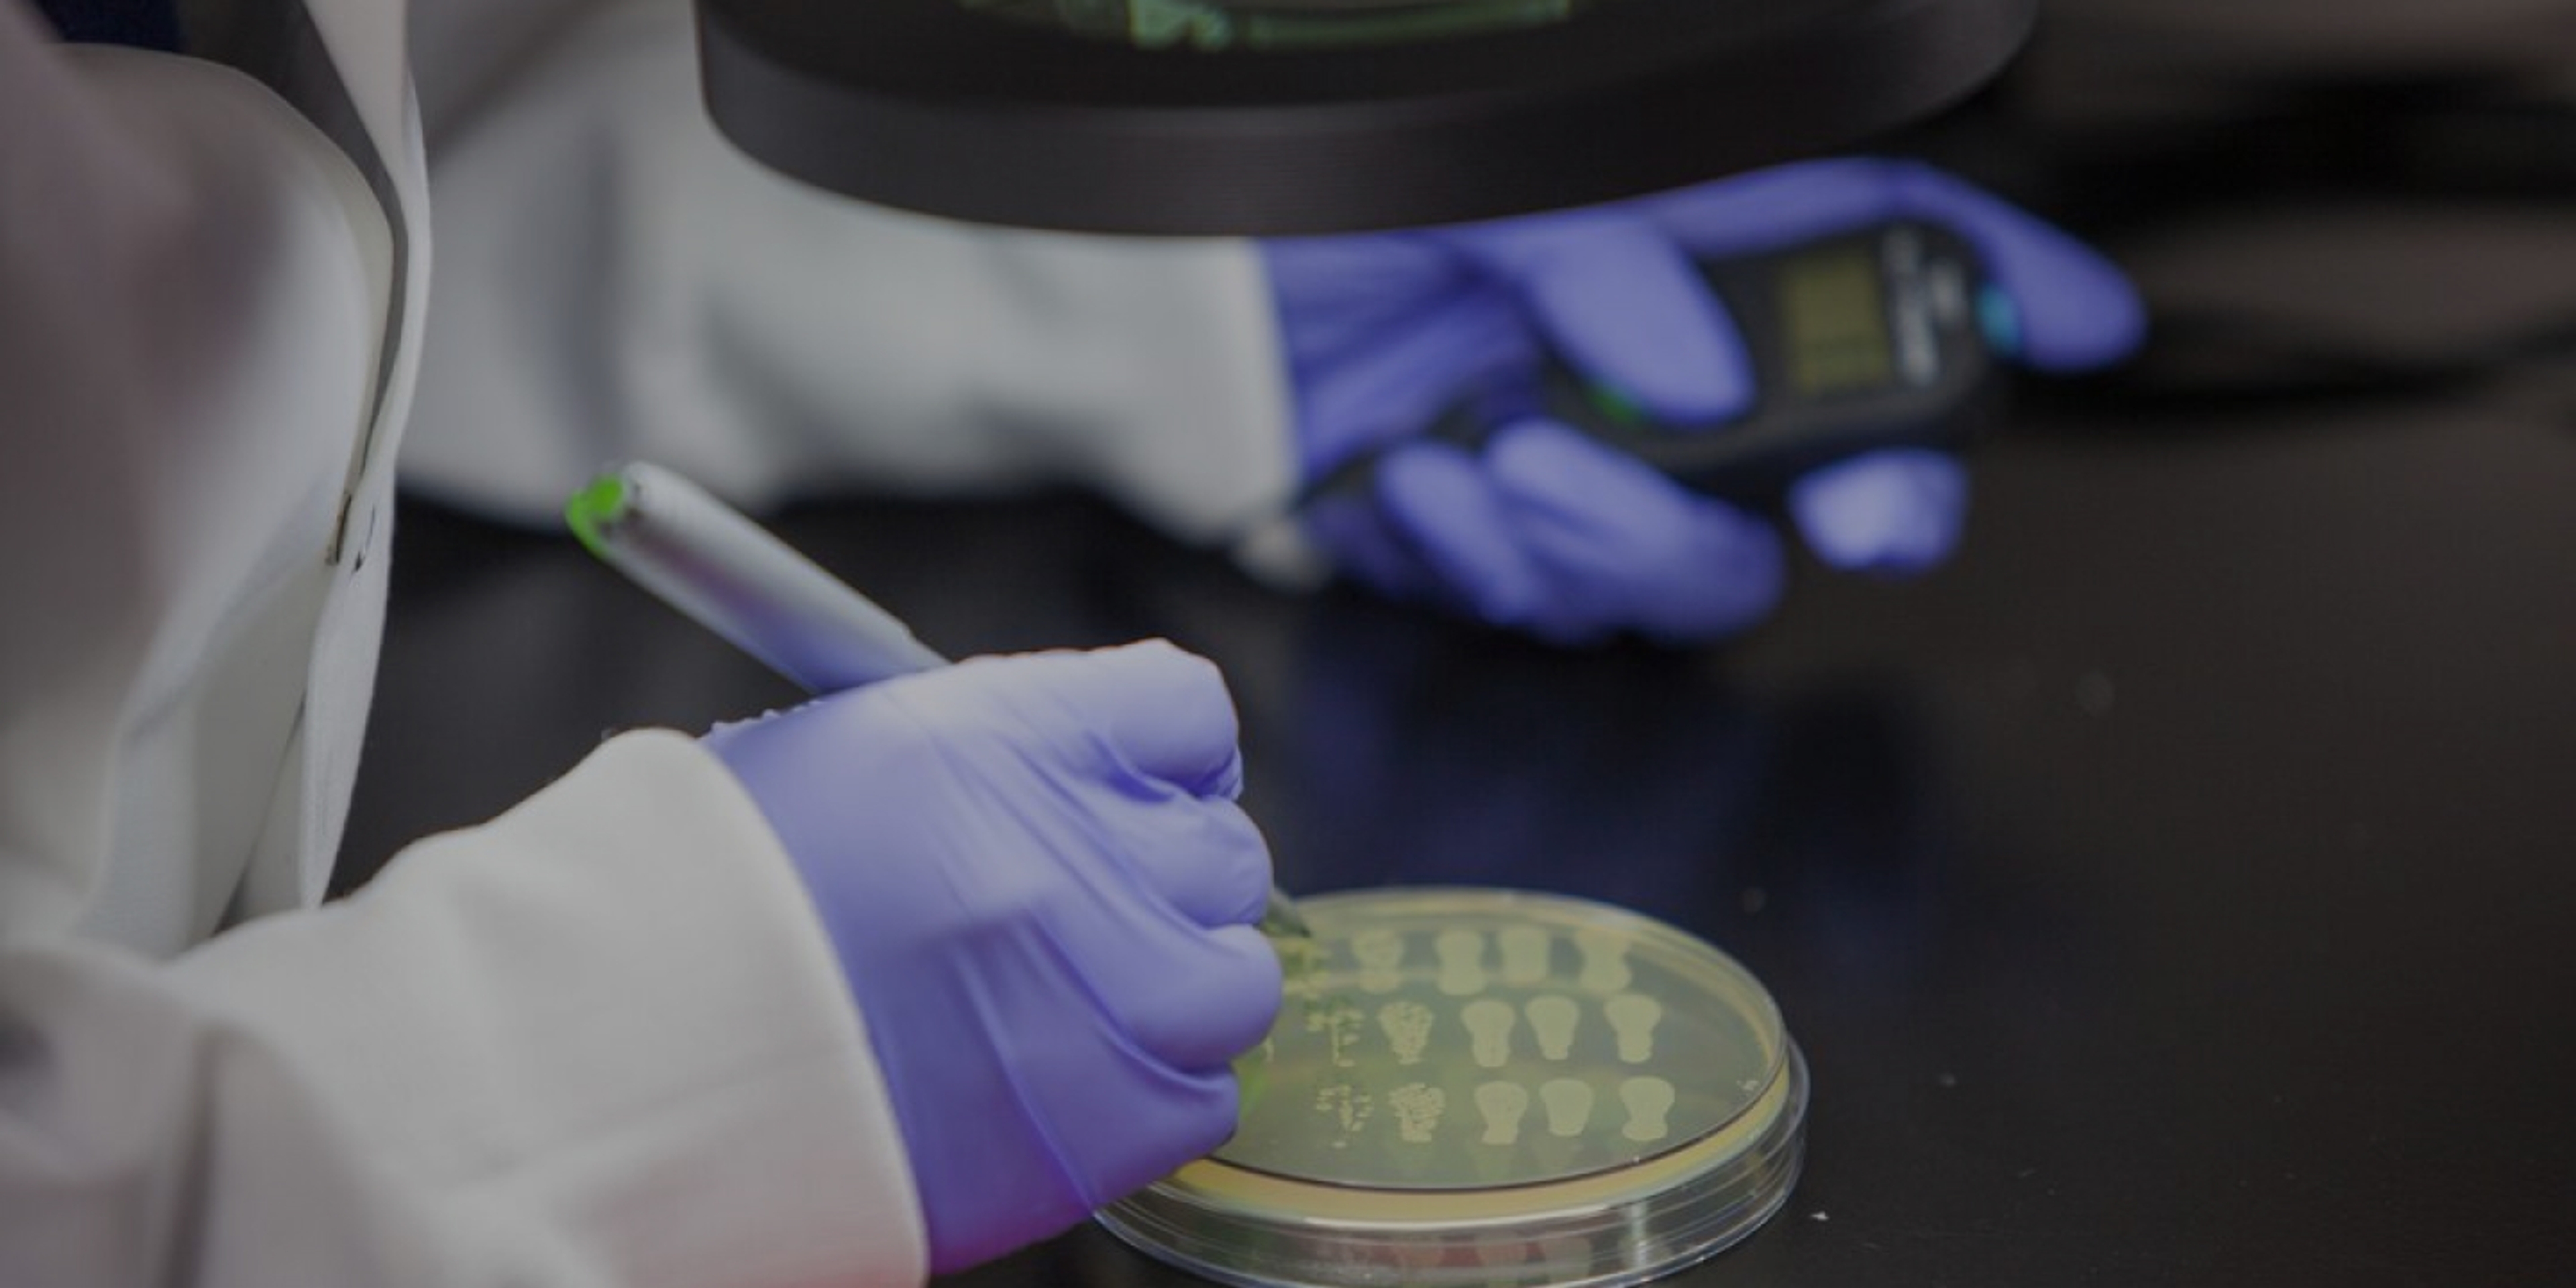
The Benefits of Microbial Fertilizer

Sustainability & Impact
A Promising Climate Solution
Growing crops to sustain billions more people and reducing emissions are among the grand challenges of our time. Key to both is nitrogen: nitrogen fertilizers are essential to generate the crop yields we can’t live without; yet they can also lead to greenhouse gas emissions and reduce water and air quality.
Pivot Bio is a solution at this intersection. It’s what future-positive agriculture means to us: helping farmers grow the crops the world needs, reliably and sustainably, in the face of increasing volatility.
Pivot Bio's Impact
Nitrogen pollution is a critical environmental challenge because it impacts so many areas: air and water pollution, biodiversity loss, ozone layer depletion and human health. The glass-half-empty view is that it makes all of these worse. The glass-half-full view is that if we better manage our relationship with it, the positive impacts are far-reaching.

Building A Nitrogen Plan Is Complex
The type of nitrogen that's used and when it is applied makes a difference to the environment and a farm's performance.
How Pivot Bio Is Transforming Nitrogen Production
How Pivot Bio Improves Grower's Nitrogen Use Efficiency
As a mom, a farmer, and a Pivot Bio employee, I believe that committing to always doing things a little bit better—not just for us, but for our environment and our community—is the only way to live. My husband, Ryan, and I farm in Marshall County, Iowa. We grow primarily corn, but we also raise hay, feeder cattle, and, our most important crop: our two kids.

Farmer Profile: Eden Ridge Farms
Farmer Profile: Titman Farms
Our Mission
Culture of Innovation


Farmers across the globe rely on nitrogen to deliver the yields necessary to sustain the food supply. Yet synthetic fertilizer is inaccessible to much of the world due to its supply chain infrastructure and high cost.
We’re committed to creating a more equitable nitrogen landscape for growers globally. Unlike synthetic fertilizer, microbial nitrogen can be manufactured domestically within any country. Microbial nitrogen also has a 1,000 times weight reduction compared to the fertilizer it replaces, a game changer for the supply chain. With more affordable, more accessible nitrogen—nitrogen whose price isn’t dictated by fossil fuel volatility or global shocks to supply chains—we can change the way our world grows food.
As we look forward, we will continue to expand our commercial registration into other countries where agriculture contributes to 33% of GDP and employs more than 40% of the total population.

Transforming Ag Is A Team Sport
Thank you to our customers, reps, employees, and partners who made this impact possible.